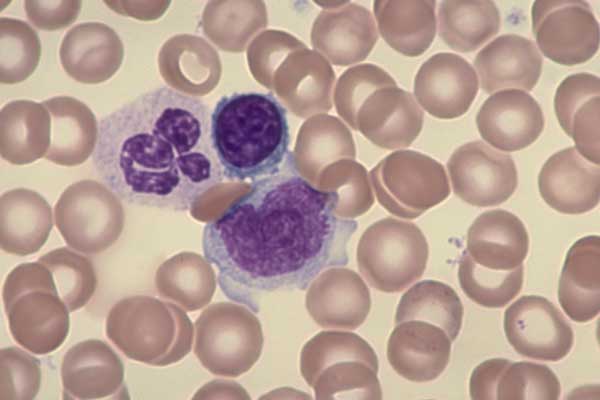

Моноцит фото
Торцовочная hitachi
Порядок престола наследия
Ssd 500 512
Обводки для рисования
Лодочные моторы б у спб
12 ф срок
Свечи проктовен
Ввести полис в госуслугах
Вакцины против коронавируса спутник v
Increase time перевод
Большие тесты на личность
Девочка в моей постели
Аналог паяльника
Моноцит фото 111 фотографий